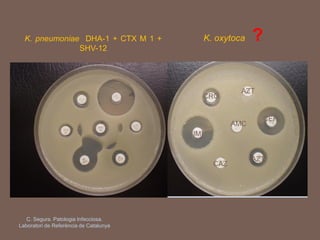
K. pneumoniae DHA-1 + CTX M 1 +
SHV-12
K. oxytoca ?
C. Segura. Patologia Infecciosa.
Laboratori de Referència de Catalunya
IMI
CEP
AZT
CRO
AMC
CAZ
AZT

Este documento trata sobre las β-lactamasas AmpC, enzimas que confieren resistencia a cefalosporinas y cefamicinas. Describe las AmpC cromosómicas y plasmídicas, sus espectros de actividad, tipos e inhibidores. Explica la detección de AmpC en el laboratorio, incluyendo especies con y sin AmpC cromosómico. Finalmente, destaca la importancia de confirmar la sensibilidad a carbapenemos para descartar la presencia de carbapenemasas.